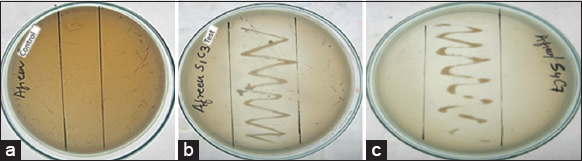

ARTICLE HIGHLIGHTS
Isolation and characterization of Pb resistant bacteria from Gomati River, Lucknow
Analysis of physico-chemical parameters of samples to check the water quality
Assessment of Pb degradation capacity of selected isolates and its plasmid profiling
Comparative analysis of bacterial isolates with other heavy metals and determination of MIC values
1. INTRODUCTION
Water contamination is a growing environmental concern caused by human activities such as the release of untreated sewage and industrial and household waste directly into water bodies, particularly rivers in India [1]. This contamination leads to uneven levels of suspended solids, altered biochemical oxygen demand (BOD), and chemical oxygen demand (COD), as well as increased accumulation of harmful pollutants such as sulphate, lead, chromium, copper, cadmium, and manganese, above permissible limits [2]. Among these, lead (Pb) is of particular concern due to its pervasive and dangerous nature, as it can cause serious health issues and environmental problems [3]. Lead toxicity affects the nervous system and can cause cardiovascular disease, renal failure, and other health problems [4]. The severity of lead toxicity is determined by the duration and intensity of exposure, as well as the mode of consumption, which can include drinking lead-contaminated water, eating lead-contaminated food, or inhaling it directly from the environment [5].
Various physical and chemical remediation techniques, including adsorption, coagulation-flocculation, membrane filtration, electrocoagulation, and photocatalysis, have been employed to minimize and reduce water pollutants [6,7]. However, these physiochemical technologies have the drawback of high cost of operation and also the involvement of chemicals and inorganic contaminants, which leads to the production of secondary waste [8]. Thus, it is very crucial to find sustainable and cost-efficient means of remediation has become an essential priority. This entails exploring new methodologies and technologies that can successfully eliminate pollutants and mitigate the environmental impact of water pollution.
Microbial remediation is an environmental-friendly technique that uses microorganisms to detoxify or remove pollutants from water bodies [9]. Some microbial species, such as Pseudomonas aeruginosa, Bacillus subtilis, and Staphylococcus epidermidis, have been found to possess the ability to remediate lead contamination in water bodies [10-12]. The tolerant mechanism adopted by these microorganisms includes biosorption, bioaccumulation, and biomineralization [8], which convert the contaminants into less toxic components. Thus, it is decisive to isolate and characterize heavy metal-resistant bacteria that can efficiently accumulate metal and resist its toxicity. By understanding the capabilities of these microorganisms, we can develop effective bioremediation strategies to address water contamination and promote a sustainable environment.
In this study, we aimed to investigate the potential of naturally occurring bacteria to detoxify and reduce lead levels from hotspot areas of the Gomati River, Lucknow, India.
2. MATERIALS AND METHODS
2.1. Sampling Area
The River Gomati flows centrally through Lucknow city from west to east, covering a distance of around 5 km. A total of five sampling sites were selected for this study. These are the Baikunth Dham (site I), Riverfront (site II), Hanuman Setu-(site III), Shaheed Smarak-(site IV), and Dali Ganj-(site V) [Table 1]. The precise locations where the samples were collected can be visualized on the map provided in Figure 1.
Table 1: Geographical location of the sampling sites.
| Site code | Site name | Latitude | Longitude |
|---|---|---|---|
| S-1 | Baikunth Dham | 26.8579° N | 80.9671° E |
| S-2 | Riverfront | 26.8546° N | 80.9706° E |
| S-3 | Hanuman Setu | 26.8606° N | 80.9374° E |
| S-4 | Shaheed Smarak | 26.8633°N | 80.9284° E |
| S-5 | Dali Ganj | 26.8728°N | 80.9276° E |
 | Figure 1: Locations of sampling area: (a) Baikunth Dham, (b) Riverfront, (c) Hanuman Setu, (d) Shaheed Smark (e) Daliganj. [Click here to view] |
2.2. Samples Collection
Approximately 500 mL of water samples were collected from each location along the Gomati River, Lucknow, and labeled as S1 to S5. All Water samples from the Gomati River were collected in five replicates from each sampling site in clean 2.0 L pre-sterilized plastic bottles during June and July 2018. River water samples were collected 5 m downstream, approximately 2 m toward the middle of the stream, from the point where the drain was mixed with the river water and subsequently transported to the Environmental Biology Laboratory, Integral University, Lucknow. The collected samples were stored at a temperature of 4°C both before and during the duration of the study.
2.3. Physiochemical Analysis of Collected Samples
The physiochemical analysis of the five collected water samples was carried out according to the American Public Health Association’s standard methodology [13]. COD was determined using spectroscopic analysis at 600 nm based on the oxidation of organic compounds by K2Cr2O7, which is transformed to potassium chromate in the presence of HgSO4 and AgSO4 (K2CrO4). Biological oxygen demand (BOD) levels were determined using a standard procedure for determining the relative oxygen requirements of wastewater, effluents, and polluted waters. The testing methods used for determining the levels of total dissolved solids (TDS), hardness, and pH were titrimetric and colorimetric techniques.
2.4. Screening of Lead-resistant Bacteria
For identification of lead-resistant bacteria, Luria Broth (LB) agar plates (dextrose anhydrate 10.0g/L, peptone 10.0g/L, NaCl 5.0g/L, yeast extract 5.0 g/L and PbNO3 300 μg /mL) were prepared for screening for bacterial isolates. To isolate the desired strains, a streaking method was used after serial dilution [14]. A control plate containing LB media with no PbNO3 were also incubated. After a 24-h of incubation period, the plates were examined for signs of positive growth. Colonies with specific morphological traits were chosen, collected, purified, and stored for further study.
2.5. Heavy Metal Consumption and Bacterial Growth
The optimum growth conditions were determined by using various concentrations of lead. Simultaneously, selected bacterial isolates were also tested for their resistance against copper (Cu) and mercury (Hg). The isolates were cultured separately in LB broth medium enriched with different heavy metals using a rotating shaker (Wise cube, Korea) at 120 rpm, pH 7.0, and 37°C. The heavy metal concentration was gradually increased from 100 μg/mL to 1000 μg/mL. After 8 h of incubation, the effect of heavy metal content on growth was assessed by taking optical density at 600nm using a UV spectrophotometer (Shimadzu, Japan) [15].
2.6. Minimum Inhibitory Concentration (MIC) Determination
To evaluate the MIC of corresponding heavy metals, the cultures were grown on heavy metal incorporated media (LB) with increasing concentrations of heavy metal starting from 50 μg/mL until the bacteria failed to form colonies. The MIC was determined by the growth of bacteria not observed on culture plates even after 5 days of incubation [16].
2.7. Lead Biodegradability Capacity of Selected Isolates
The bacterial strains were cultured in LB broth media (pH-7; 37°C) in a shaking flask for 60 min in an orbital shaker at 120 rpm. When the optical density reached 0.6 (lambda max = 600 nm), 100 ppm of lead was added to the culture flask, and the cells were allowed to grow for another 24 h under the same conditions. Afterward, the entire culture was spun at 5000 rpm for 15 min using a Sigma 2-16KL (Germany) centrifuge. The supernatants were collected, and a double volume of concentrated HNO3 (0.1N) was added. The total lead degradation was measured using an atomic absorption spectrophotometer (Shimadzu AA-7000, Japan) after diluting it to its initial concentration, and the results were compared to the control to determine the heavy metal degrading capacity, as follows [17].
 |
2.8. Morphology and Biochemical Characterization of Selected Isolates
The bacterial strains were identified using Cowan and Steel’s Manual for the Identification of Medical Bacteria, which involves the use of cultural, biochemical, and morphological characteristics [18]. Precisely, the isolates were subjected to various biochemical tests, including catalase, oxidase, indole synthesis, methyl red, citrate consumption, and carbohydrate (glucose, sucrose, maltose, xylose, lactose, and xylose) utilization tests.
The identification of the bacterial strains was based on the guidelines outlined in Bergey’s Manual of Systemic Bacteriology, which is a comprehensive reference work for bacterial taxonomy [19]. While the strains were tentatively recognized up to the genus level, further testing and analysis may be required to confirm their species identity.
2.9. 16S rRNA Gene Sequencing and Phylogenetic Analysis
Using the HiPer® Bacterial Genomic DNA Extraction Kit (HiMedia -India), the genomic DNA of S4C7 and S1C3 bacterial strains was extracted. The 16S rRNA gene was amplified using a Polymerase chain reaction (PCR) thermal cycler (Eppendorf). DNA (4 μL), forward and reverse primer (2 μL for each), master mix (6 μL) and distilled water (6 μL) for total volume of 20 μL of reaction mixture were taken for PCRs with initial denaturation at 94°C for 5 min, followed by 35 cycles of denaturation at 94°C for 1 min, annealing at 55°C for 45 s, extension at 72°C for 1 min, and final extension at 72°C for 10 min. Using two universal oligonucleotide bacterial primers, 16S rRNA forward primer (5-AGAGTTTGATCCTGGCTCAG-3’) and 16S rRNA reverse primer (5’AAGGAGGTGATCCAGCCGCA-3’), PCR amplification of the 16S rRNA gene was carried out and amplified PCR products were sent for sequencing by the dideoxy-chain termination method to Bio Innovations, Mumbai, India. A sequence identity search was performed by using BLAST [20]. Phylogenetic analysis was performed using the Molecular Evolutionary Genetics Analysis software. The phylogenetic tree was constructed using the neighbor-joining tree method [21], and the genetic distance model was developed by using the Tamura-Nei model [22].
2.10. Plasmid DNA Extraction
Plasmid DNA extraction from lead-resistant bacteria was done according to the alkaline lysis method [23]. Then visualized it on gel electrophoresis at 1% agarose gel and compared it with marker DNA (1kbp sharp DNA Marker- RBC Bioscience) to assess plasmid DNA.
2.11. Statistical Analysis
The tests were performed in triplicate, and the data was statistically analyzed using Graph Pad Prism (Ver.9). Analyses of variance were performed as necessary to compare the data obtained statistically. The Student’s t-test was applied to make sure the observed improvements were statistically significant.
3. RESULTS
3.1. Analysis of Physiochemical Parameters (BOD, COD, TDS, Hardness, and pH) of Collected Samples
BOD is defined as the amount of dissolved oxygen needed by aerobic biological organisms in a body of water to break down the organic material present in a water sample at a specific temperature and specified period. BOD is a method used to evaluate water quality by calculating the oxygen requirement for decomposing its organic matter. The highest BOD values were found in samples collected from site S4 (24.67 mg/L), while the minimum BOD values were observed in samples from site S2 (14.33 mg/L). Samples from sites S1, S3, and S5 had BOD values of 19.33, 22.12, and 21.67 mg/L, respectively. Similarly, COD is the only method that gives idea about organic load in water. It is the amount of oxygen needed to oxidize organic and inorganic matter present in water by utilizing oxidizing agents such as potassium permanganate, potassium dichromate, etc. Like BOD, the highest COD value was observed in S4 (358.67 mg/L) samples, followed by sites S1 (327.21 mg/L), S3 (259.67 mg/L), and S5 (233.24 mg/L). TDS outlined the presence of total inorganic compounds along with organic matter. From the results, it could be inferred that TDS had a peak tendency in S2 (437.67 mg/L) and S3 (431.33 mg/L), while the minimum TDS was observed in S4 (308.3 mg/L). A summary of the comparative analysis of the physicochemical parameters of the collected samples is presented in Table 2.
Table 2: Water quality analysis of collected samples.
| Parameters | Site-S1 | Site-S2 | Site-S3 | Site-S4 | Site-S5 |
|---|---|---|---|---|---|
| BOD (mg/L) | 19.33±2.08 | 14.33±2.08 | 22.12±2.65 | 24.67±4.51 | 21.67±2.08 |
| COD (mg/L) | 327.21±8.19 | 245.23±5 | 259.67±1.53 | 358.67±9.61 | 233.24±18.01 |
| Hardness | 118±7.21 | 133.67±3.21 | 148.33±9.07 | 176±8.57 | 156.67±2.31 |
| TDS (ppm) | 312.3±2.52 | 437.67±2.52 | 431.33±10.02 | 308.3±7.64 | 432±15.72 |
| pH | 6.13±0.32 | 5.02±1.2 | 6.87±0.32 | 6.13±0.59 | 7.33±0.29 |
3.2. Selection of Lead-resistant Bacteria
Isolation of lead-resistant strain was done through the enrichment culture technique using the LB broth containing 300 μg/mL of lead as lead (II) nitrate. After 24 h incubation, only twenty bacterial isolates were found to exhibit growth in the presence of lead. From these isolates, two isolates S1C3 and S4C7, were selected based on maximum growth of bacteria on given media and zone of hydrolysis for further investigation [Figure 2].
| Figure 2: Visual growths of selected bacteria on lead comprising media: (a) Control media comprising lead, (b) growth of S1C3 on media comprising lead, (c) growth of S4C7 on media comprising lead. [Click here to view] |
3.3. Comparative Study on Multiple Heavy Metal Degradation Ability of Selected Isolates
The growth analysis and resistance capability tests were conducted to assess the resistance of chosen bacterial isolates (S1C3 and S4C7) to other heavy metals copper and mercury, along with lead. The outcomes indicated that S1C3 had a very good potential to tolerate and degrade lead, mercury, and Cu. Conversely, S4C7 exhibited higher resistance to Pb and Cu but was found to be sensitive to Hg [Figure 3a-c].
 | Figure 3: Growth analysis of selected isolated in LB media supplemented with heavy metals. (a)-Growth of isolate in Pb-supplemented media, (b)-Growth of isolate in Hg-supplemented media; (c)-Growth of isolate in Cu-supplemented media. Data are mean ± SD (n = 3) (P ≤ 0.05). [Click here to view] |
3.4. Determination of MIC of Heavy Metals
Depending on the outcomes, the order of the MIC values for the chosen isolates varied. For S1C3, the order of MIC was highest for Pb, followed by Hg and then Cu, with values of 1800 μg/mL, 1250 μg/mL, and 356 μg/mL, respectively. This indicates that S1C3 is most resistant to Pb toxicity, followed by Hg and Cu.
On the other hand, the order of MIC values for isolate S4C7 was different, with the highest MIC observed for Pb, followed by Cu and then Hg. Specifically, the MIC values for S4C7 were 1200 μg/mL for Pb, 325 μg/mL for Cu, and 20 μg/mL for Hg, indicating that S4C7 exhibited resistant to Pb toxicity, followed by Cu and then Hg [Figure 4].
 | Figure 4: Minimum inhibitory concentrations of Pb, Cu, and Hg for the selected bacterial isolates. [Click here to view] |
3.5. Lead Degradation Potential of Selected Isolates
The results of the Atomic Absorption Spectrophotometer analysis showed that S1C3 exhibited a significantly higher lead degrading ability compared to S4C7. Precisely, the lead degradation rate of S1C3 was found to be nine times higher (p < 0.05) than that of S4C7 [Figure 5].
 | Figure 5: Percentage degradation of heavy metal (Pb) through isolated bacterial strains. [Click here to view] |
3.6. Identification of Heavy Metal-Resistant Bacterial Isolates
From the results, the morphological and biochemical characteristics of the isolated bacterial species revealed that the two isolates were provisionally identified up to the genus level as S1C3 was identified as a Gram-negative coccus and S4C7 was identified as a Gram-positive bacillus [Table 3]. This analysis allowed for the accurate classification and identification of the bacterial strains, which is essential for further research and analysis of their biochemical and genetic properties.
Table 3: Morphological and biochemical characterization of S1C3 and S4C7.
| Tests | S1C3 | S4C7 |
|---|---|---|
| Morphological identification | ||
| Catalase | Positive | Positive |
| Gram staining | Negative | Positive |
| Spore formation | Negative | Positive |
| Shape | Coccus | Rod |
| Mannitol | Negative | Negative |
| Indole | Negative | Negative |
| Methyl red | Positive | Negative |
| Voges Proskauer | Negative | Positive |
| Urease | Negative | Positive |
| Biochemical Characterization | ||
| Glucose fermentation | Positive | Positive |
| Lactose | Positive | Positive |
| Xylose | ND | |
| Maltose | Positive | ND |
| Sucrose | Positive | Positive |
| Resistance capacity | ||
| Pb | +++ | +++ |
| Cu | ++ | +++ |
| Hg | +++ | + |
| Provisionally identified bacteria | Staphylococcus spp. | Bacillus spp. |
3.7. Molecular Characterization and Phylogenetic Analysis of Selected Isolates
After conducting 16s rRNA sequencing studies and performing partial sequence comparison using NCBI BLAST, S1C3, and S4C7 isolates were identified as Stenotrophomonas maltophilia and Paenibacillus dendritiformis, respectively. The amplified DNAs were then sequenced and compared to those in the Gene Bank database. The comparison showed that strain S1C3 has 94.85% identity and strain S4C7 has 96.65% identity, which was then submitted to the NCBI (Accession No. OP835924 and OP835923). A phylogenetic tree was constructed based on the 16S rRNA gene sequences, and it is presented in Figure 6.
 | Figure 6: Rooted phylogenetic trees showing the relationship of the 16S rRNA sequence using the neighbor-joining method (bootsrap values were ran at 1000 replications) Figure 6(a)-S1C3 and 6(b)-S4C7. [Click here to view] |
3.8. Plasmid DNA Extraction
The agarose gel electrophoresis analysis revealed that both S1C3 and S4C7 isolates contained plasmid DNA with a base pair length of 6500bp. However, S4C7 showed a more prominent band than S1C3, as depicted in Figure 7. The intensity of the band for S1C3 was found to be less pronounced than that of S4C7 [Figure 7].
 | Figure 7: Plasmid profile of lead-resistant bacteria S1C3 and S4C7 (Lane 1: S1C3 strain, Lane 2: S4C7 strain Lane 3, 1 kb DNA ladder marker). [Click here to view] |
4. DISCUSSION
Industrial development and advances in technology have increased the impact on the environment by releasing significant amounts of dangerous materials and heavy metals (such as Cd, Cr, and Pb), metalloids, and organic pollutants that have caused significant harm to the ecosystem [24]. Lead is a non-essential element and extremely harmful to humans, animals, plants, and microorganisms [25]. The aim of this study was to isolate and identify bacterial agents capable of aiding in the natural recovery of agricultural and residential environments by remediating heavy metals in general and lead pollutants in particular. The sampling sites were carefully selected based on their status as major sources of heavy metal pollutants, including industries, electric crematoriums, and dumping of religious materials and temple wastes [26].
The sampling area, Baikunth Dham, was identified as a significant source of heavy metals due to electric crematorium effluents and Kukrail Nala effluents. Direct discharge of municipal waste into the riverfront was found to be another source of heavy metal pollution. Hanuman Setu temple effluents were also identified as one of the sources of heavy metal contamination. Shaheed Smarak, where Gomeshwar Shiv Mandir effluents were found, was also identified as a source of heavy metal contamination, and at Daliganj Setu, where the fruit market and temple effluents contributed to heavy metal pollution [2,26].
During the preliminary screening, several physiochemical parameters of the collected samples, such as BOD, COD, TDS, hardness, and pH, were analyzed. On analyzing the results, it was found that site-4 (Shaheed Smark) had the highest BOD and COD levels, which could have resulted from the Gomeshwar Shiv-Mandir effluent area as well as the municipal waste loads. This high level of BOD and COD requires a greater amount of oxygen for chemical oxidation and decomposition. These results are correlated with the finding of Pathak and Patel [26]. The lower dissolved oxygen levels lead to anoxic conditions, a lack of nutrient availability, an increase in the loading of organic substances, and an increase in pathogens in the water bodies. A high BOD level also indicates the presence of a large number of bacteria or other microorganisms in the water, which may have been introduced by domestic and industrial wastewater, thereby increasing the BOD in the river water [27]. These findings are significant as they highlight the potential negative impact of human activities on the water quality and call for the need to adopt measures to mitigate such pollution.
Unfortunately, all of the selected sites were found to have exceeded the permissible limits set by the Uttar Pradesh Pollution Control Board, Lucknow, as reported on their website (http://www.uppcb.com/river_quality.htm) [28]. The high TDS levels found at riverfront sites were attributed to the discharge of toxicological additives and municipal waste, rendering the water unsuitable for domestic and agricultural use. In addition, the high TDS load was found to be ineffective in reducing the nutrient load of urban wastewater, thereby contributing to the degradation of the River’s water quality [29]. The pH of the water was also found to fluctuate significantly over time due to factors such as changes in temperature, exposure to air, and biological activity.
These water samples were further examined for the isolation of lead-tolerant indigenous bacteria. In the initial screening, 20 bacterial isolates were isolated by consuming culture media with lead supplements. Out of 20 isolates, two isolates, S1C3 and S4C7, were found to possess significant lead-resistant potential and chosen for further research due to their maximum lead-consumption capacity (Data not shown).
S. maltophilia has been previously reported to have tremendous bioremediation potential for heavy metals such as Pb and Hg [30]. In line with these findings, our study showed that S1C3 (S. maltophilia) has a high capacity for Pb and Hg detoxification. However, it is worth assuming that new genetic modifications might prove to be beneficial to make such microorganisms effective and more efficient in removing these compounds, which were previously thought to be recalcitrant.
On the other hand, P. dendritiformis has been reported to be a useful tool for mitigating heavy metal toxicity such as Pb, Cu and Zn [31]. Our study also found that S4C7, which is identified as P. dendritiformis, had a good potential to sequester Pb from contaminated water. This is in line with previous research indicating that Paenibacillus spp. can efficiently reduce heavy metal pollution in the environment [32].
The multiple heavy metal resistance of both strains was also investigated in the study, which revealed that the biomass of bacterial strains decreased with increasing heavy metal levels. The growth of bacteria was monitored in the presence of heavy metal(s) and it depicted that P. dendritiformis was less resistant to Pb and Cu than Stenotrophomona smaltophilia, while more sensitive to higher concentrations of Hg. In contrast, S. maltophilia (S1C3) showed greater resistance and tolerance to Pb and Cu (p ≤ 0.05).
These findings highlight the diverse abilities of different bacterial strains in responding to heavy metal pollution in the environment and the need for careful consideration of the microbial community when developing strategies for heavy metal remediation. It was evident from previous studies that many bacteria had great potential for resistance to various heavy metals such as Zn, Pb, Cu, and Hg. Among them, Micrococcus luteus was discovered to be the most multi-metal resistant [33,34]. Based on previous findings, it was observed that P. dendritiformis exhibited the lowest capacity for reducing Pb and Cu, and also displayed sensitivity toward Hg [35]. Recently, EDX analysis combined with FT-IR analysis revealed that the SY-2 strain of S. maltophilia has significant metal tolerance and bioremediation potential against cadmium [36].
Heavy metal resistance in bacterial strains can be attributed to plasmid-mediated or chromosomal DNA-mediated mechanisms, and plasmid profiling is required to determine the genetic basis of metal resistance [17]. P. dendritiformis has been found to possess a prominent band (6500 bps) in isolates, which confers strong degrading capability, possibly due to plasmid-holding resistance [37]. Heavy metal resistance genes can be found on the chromosome, plasmids, or both, with plasmid resistance being more commonly conferred [38]. These genes are coding proteins that are associated with transferring and sequestering heavy elements in the intercellular space and cell surface of bacterial, thus reducing the negative effects of heavy metals [39]. However, some Pb-resistant genes have also been discovered in Enterobacteria chromosomal DNA [40]. Therefore, further studies are needed to fully understand the mechanisms of heavy metal resistance in bacterial strains and their potential for bioremediation. However, detailed mechanisms linked with the detoxification of heavy metals are not yet fully explored. Even though basic research will allow plasmid curing, heavy metal resistance transformation, and assessment can pave the way for the genetic foundation of heavy metal resistance mechanisms. The findings from this study could potentially be used to recover future pollution caused by untreated heavy metal-containing effluent.
5. CONCLUSION
The water pollution level in the Gomati River was found to be extremely high, indicating the poor quality of water, which makes it dangerous and unsuitable for any use. All of the indices are above average, raising serious concerns about the river ecosystem. The river ability to purify itself was compromised due to the massive volume of organic and inorganic waste, which resulted in an increase in bacterial proliferation.
The isolation and characterization of beneficial microorganisms is a promising strategy for pollution reduction. Based on the above findings, it can be concluded that isolated bacterial strains S. maltophilia, and P. dendritiformis could be used to remediate lead from wastewater.
6. ACKNOWLEDGMENT
The authors are grateful to Integral University, Lucknow, and DST-FIST funding (SR/FST/LS-1/2017/13(C), for providing research facilities to the department. The authors are also indebted to the Department of Doctoral Studies, Integral University, Lucknow, for quick and crisp revision of the manuscript, needful suggestion, and for allotting manuscript number IU/R&D/2022-MCN0001602.
7. AUTHORS’ CONTRIBUTIONS
All authors made substantial contributions to the conception and design, acquisition of data, or analysis and interpretation of data; took part in drafting the article or revising it critically for important intellectual content; agreed to submit to the current journal; gave final approval of the version to be published; and agreed to be accountable for all aspects of the work. All the authors are eligible to be an author as per the International Committee of Medical Journal Editors (ICMJE) requirements/guidelines.
8. CONFLICTS OF INTEREST
The authors report no financial or any other conflicts of interest in this work.
9. ETHICAL APPROVALS
This study does not involve experiments on animals or human subjects.
10. DATA AVAILABILITY
Data that support these findings are available within the article.
11. PUBLISHER’S NOTE
This journal remains neutral with regard to jurisdictional claims in published institutional affiliation.
REFERENCES
1. Mukate S, Panaskar D, Wagh V, Muley A, Jangam C, Pawar R. Impact of anthropogenic inputs on water quality in Chincholi industrial area of Solapur, Maharashtra, India. Groundwater Sustain Dev 2018;7:359-71. [CrossRef]
2. Kumar A, Bojjagani S, Maurya A, Kisku GC. Spatial distribution of physicochemical-bacteriological parametric quality and water quality index of Gomti river, India. Environ Monit Assess 2022;194:159. [CrossRef]
3. Wani AL, Ara A, Usmani JA. Lead toxicity:A review. Interdiscip Toxicol 2015;8:55-64. [CrossRef]
4. Mitra P, Sharma S, Purohit P, Sharma P. Clinical and molecular aspects of lead toxicity:An update. Crit Rev Clin Lab Sci 2017;54:506-28. [CrossRef]
5. Kushwaha A, Hans N, Kumar S, Rani R. A critical review on speciation, mobilization and toxicity of lead in soil-microbe-plant system and bioremediation strategies. Ecotoxicol Environ Saf 2018;147:1035-45. [CrossRef]
6. Sahu JN, Mazumder P. Recent Developments and Challenges in Membrane-based Water Treatment Processes. Water Conservation, Reuse, and Recycling. In:Proceedings of the International Conference on Water Conservation, Reuse, and Recycling, ICWCRR;2019. 163-73.
7. Mohapatra M, Santra SC, Sahu JN, Bansal M. Application of coagulation-flocculation in water and wastewater treatment:A review. J Environ Chem Eng 2021;9:106122.
8. Shahid A, Pandey C, Ahmad F, Kamal A. Bacterial bioremediation:Strategies adopted by microbial-community to remediate lead from the environment. J Appl Biol Biotechnol 2021;9:18-24. [CrossRef]
9. Azubuike CC, Chikere CB, Okpokwasili GC. Bioremediation techniques-classification based on site of application:Principles, advantages, limitations and prospects. World J Microbiol Biotechnol 2016;32:180. [CrossRef]
10. Nabti S, Merzouk B, Moulessehoul S, Moulessehoul A, Hamoudi S. Bioremediation of lead-contaminated soil using Pseudomonas aeruginosa strain LZ-4:Optimization of medium parameters. Environ Sci Pollut Res Int 2017;24:22656-69.
11. Iram S, Ali N, Hussain M. Isolation and characterization of lead-resistant Bacillus subtilis from contaminated soils for bioremediation of heavy metal-contaminated soil. Microb Ecol 2020;80:476-90.
12. Sun Q, Li S, Sun C, Luo X. Staphylococcus epidermidis SR15-1, a novel isolate capable of degrading heavy metal and reducing oxidative damage. J Hazard Mater 2021;404:124144.
13. APHA. Standard Methods for the Examination of Water and Wastewater. Washington, D.C.:American Public Health Association;2017.
14. Marzan LW, Hossain M, Mina SA, Akter Y, Chowdhury AM. Isolation and biochemical characterization of heavy-metal resistant bacteria from tannery effluent in Chittagong city, Bangladesh:Bioremediation viewpoint. Egypt J Aquat Res 2017;43:65-74. [CrossRef]
15. Khare S, Ahmed N, Pant S, Das R. ?Characterization and evaluation of heavy metal tolerance of bacterial species from soil of waste area near Riyan steel rolling mills, Muzaffarnagar, India. J Appl Nat Sci 2010;2:88-92. [CrossRef]
16. Kaczorek E. Effect of external addition of rhamnolipids biosurfactant on the modification of gram positive and gram negative bacteria cell surfaces during biodegradation of hydrocarbon fuel contamination. Pol J Environ Stud 2012;21:901-9.
17. Rajesh N, Rajesh V. Evaluation of the genetic basis of heavy metal resistance in an isolate from electronic industry effluent. J Genet Eng Biotechnol, 2016;14:177-180. [CrossRef]
18. Cowan ST, Steel KJ. Cowan and Steel's Manual for the Identification of Medical Bacteria. 3rd ed. Cambridge, UK:Cambridge University Press;1993.
19. Bergey DH. Bergey's Manual of Determinative Bacteriology. United States:Lippincott Williams and Wilkins;1994.
20. Altschul SF, Gish W, Miller W, Myers EW, Lipman DJ. Basic local alignment search tool. J Mol Biol 1990;215:403-10. [CrossRef]
21. Saitou N, Nei M. The neighbor-joining method:A new method for reconstructing phylogenetic trees. Mol Biol Evol 1987;4:406-25.
22. Tamura K, Nei M. Estimation of the number of nucleotide substitutions in the control region of mitochondrial DNA in humans and chimpanzees. Mol Biol Evol 1993;10:512-26.
23. Sambrook J, Russell DW. Molecular Cloning:A Laboratory Manual. 3rd ed. Cold Spring Harbor, NY:Cold Spring Harbor Laboratory Press;2001.
24. Patnaik R. Impact of industrialization on environment and sustainable solutions-reflections from a South Indian region. IOP Conf Ser Earth Environ Sci 2018;120:012016. [CrossRef]
25. Chatterjee S, Mukherjee A, Sarkar A, Roy P. Bioremediation of lead by lead-resistant microorganisms, isolated from industrial sample. Adv Biosci Biotechnol 2012;3:290-5. [CrossRef]
26. Pathak A, Patel A. Assessment of water quality of Gomti river using water quality index and GIS, in Lucknow city, Uttar Pradesh. Int J Adv Res Innov Ideas Educ 2021;7:705-15.
27. Hasan MK, Shahriar A, Jim KU. Water pollution in Bangladesh and its impact on public health. Heliyon 2019;5:e02145. [CrossRef]
28. Uttar Pradesh Pollution Control Board. Available from:http://www.uppcb.com/pdf/NWMP-data-Jan-2022_090322.pdf
29. Rahman A, Jahanara I, Jolly YN. Assessment of physicochemical properties of water and their seasonal variation in an urban river in Bangladesh. Water Sci Eng 2021;14:139-48. [CrossRef]
30. Mukherjee P, Roy P. Genomic potential of Stenotrophomonas maltophilia in bioremediation with an assessment of its multifaceted role in our environment. Front Microbiol 2016;7:967. [CrossRef]
31. Sridevi V, Raghuram M. Multiple metal tolerance of Paenibacillus dentritiformis isolated from metal contaminated soils west Godavari district (Andhra Pradesh). J Appl Nat Sci 2019;11:486-91. [CrossRef]
32. Zhang J, Jia Y, Liu Z, Cai H, Wang Q, Xiong X, et al. Biosorption of Pb (II) and Zn (II) ions from aqueous solutions using Paenibacillus amylolyticus:Isotherm, kinetics, and thermodynamics studies. Environ Sci Pollut Res 2021;28:4874-87.
33. Janda JM, Abbott SL. The genus Hafnia:From soup to nuts. Clin Microbiol Rev 2006;19:12-8. [CrossRef]
34. Igiri BE, Okoduwa SI, Idoko GO, Akabuogu EP, Adeyi AO, Ejiogu IK. Toxicity and bioremediation of heavy metals contaminated ecosystem from tannery wastewater:A review. J Toxicol 2018;2018:2568038. [CrossRef]
35. Fakruddin M, Mazumder RM, Tania TK, Islam S, Nipa MN, Iqbal A, et al. Isolation and characterization of chromate resistant and reducing bacteria from tannery effluent of Chittagong, Bangladesh. J Biosci 2009;17:71-6. [CrossRef]
36. Liaquat F, Munis MF, Arif S, Haroon U, Shengquan C, Qunlu L. Cd-tolerant SY-2 strain of Stenotrophomonas maltophilia:A potential PGPR, isolated from the Nanjing mining area in China. 3 Biotech 2020;10:519. [CrossRef]
37. Usman UZ, Mukesh Y, Vandana S, Sharma JK, Sanjay P, Sidhartha D, et al. Microbial bioremediation of heavy metals:Emerging trends and recent advances. Res J Biotechnol 2020;15:164-78.
38. Kalaimurugan D, Balamuralikrishnan B, Durairaj K, Vasudhevan P, Shivakumar MS, Kaul T, et al. Isolation and characterization of heavy-metal-resistant bacteria and their applications in environmental bioremediation. Int J Environ Sci Technol 2020;17:1455-62. [CrossRef]
39. Ashrafi Z, Heidari P, Mojerlou S. Does the long-term contamination of lead (PbII) affect the bioremediation mechanisms of Microbacterium oxydans strain CM3 and CM7?Soil Sediment Contam Int J 2022;31:959-73. [CrossRef]
40. Davis IJ, Richards H, Mullany P. Isolation of silver-and antibiotic-resistant Enterobacter cloacae from teeth. Oral Microbiol Immunol 2005;20:191-4. [CrossRef]